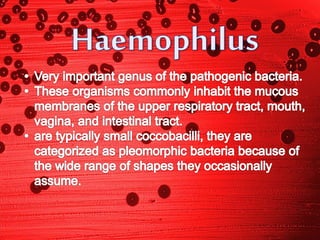

Proteobacteria is a major phylum of bacteria that includes many pathogens and bacteria responsible for nitrogen fixation. It was named after the shape-shifting Greek god Proteus. There are five main classes of Proteobacteria: Alphaproteobacteria, Betaproteobacteria, Gammaproteobacteria, Deltaproteobacteria, and Epsilonproteobacteria. Several genera of proteobacteria were then described, including Rickettsia, which live obligately within white blood cells, and Rhizobium and Bradyrhizobium, which form symbiotic nitrogen-fixing relationships with leguminous plants.